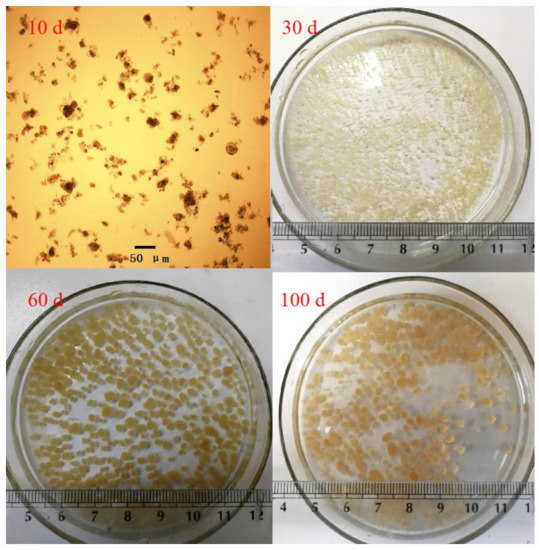

Abstract
The start-up of the aerobic granular sludge (AGS) process under low temperature is challenging. In this study, the sequencing batch reactor (SBR) was fed with synthetic wastewater and the temperature was controlled at 15 ℃. The main components in the synthetic wastewater were sodium acetate and ammonium chloride. The influent chemical oxygen demand (COD) and NH4+-N concentrations were 300 and 60 mg/L, respectively. The AGS was successfully cultivated in 60 days by gradually shortening the settling time. During the stable operation stage (61–100 d), the average effluent COD, NH4+-N, NO2−-N, and NO3−-N concentrations were 47.2, 1.0, 47.2, and 5.1 mg/L, respectively. Meanwhile, the nitrite accumulation rate (NAR) reached 90.6%. Batch test showed that the smaller AGS had higher NH4+-N removal rate while the larger AGS performed higher NAR. The NH4+-N removal rates of R1 (1.0–2.0 mm), R2 (2.0–3.0 mm), and R3 (>3 mm) granules were 0.85, 0.61, and 0.45 g N/(kg VSS·h), respectively. Meanwhile, the NAR of R1, R2, and R3 were 36.2%, 77.2%, and 94.9%, respectively. The obtained results could provide important guidance for the cultivation of AGS in low-temperature wastewater treatment.
1. Introduction
With the increasingly serious water environment pollution problem, many countries have put forward higher requirements on the nitrogen and phosphorus discharge standards [1]. Therefore, it is necessary to upgrade the existing sewage treatment process. Moreover, carbon neutrality is a key indicator towards sustainable wastewater treatment [2]. It is important to reduce energy consumption in wastewater treatment plants and develop energy-saving technologies. The traditional biological nitrogen removal was achieved through nitrification and denitrification process. Recently, the partial nitrification/anammox (PN/A) process has been developed to remove nitrogen, which requires less aeration and carbon source [3]. In the PN/A process, the ammonium was first oxidized to nitrite by ammonia-oxidizing bacteria (AOB). Then the anammox bacteria converted the ammonium and nitrite to nitrogen gas. The inhibition of nitrite-oxidizing bacteria (NOB) is one of the biggest challenges in the application of PN/A process, which needs to be further investigated.
The aerobic granular sludge (AGS) process is considered to be one of the most promising wastewater treatment technologies [4]. In the past few decades, researchers have applied the AGS process to the treatment of mainstream wastewater and industrial wastewater [5]. Aerobic granule is composed of microorganisms and extracellular polymeric substances. The AGS process has the advantages of high biomass concentration, good sedimentation performance, and energy saving. The AGS is composed of multiple layers, which makes it possible to enrich aerobic bacteria, facultative bacteria, and anaerobic microorganisms, simultaneously. Previous studies reported that the AGS reactor achieved excellent partial nitrification performance under the conditions of high temperature (30–35 °C) and high ammonium concentration (>500 mg/L) [6]. As the growth rate of AOB is greater than NOB under high operating temperature (30 °C), NOB could be washed out by controlling short sludge age [7]. For high ammonium wastewater treatment, the NOB could be severely inhibited by high free ammonia (FA) concentration (>1 mg/L), while the AOB activity was slightly suppressed [8]. In some areas, especially northern China, the mainstream waste water has a low temperature and low ammonium concentration. Temperature has a significant impact on the sludge activity and microbial population structure. Under low temperature, the growth and biological activity of microorganisms is seriously inhibited [1]. Meanwhile, the excessive reproduction of filamentous bacteria and poor sludge sedimentation performance have also been observed [9,10]. According to prior research, the AGS has been cultivated at 7 °C by inoculating cold-adapt sludge [11]. When dealing with low ammonium wastewater, low dissolved oxygen (DO) and intermittent aeration strategies were proposed to suppress the NOB activity [12,13]. Vazquez-Padin et al., (2010) reported that stable nitrite accumulation could be achieved in the AGS reactor at room temperature (24 °C) [14]. As described by Zhang et al., (2018), the NOB activity of the AGS reactor was successfully inhibited by operating anaerocic/aerobic mode [15]. The nitrite accumulation ratio reached 97.3% when the influent NH4+-N concentration was 39.3–78.7 mg/L. So far, the cultivation of partial nitrification AGS under low temperature and low ammonium concentration was rarely reported. Moreover, the high mass transfer resistance of granules led to low DO concentration in AGS, which was considered as the major reason for NOB inhibition [16]. However, due to the technical limitation, the earlier research mainly analyzed the DO distribution in AGS through model fitting [17,18]. Later, the DO distribution in granules under room temperature operation was explored with microelectrode device [16,19]. The DO distribution in AGS was closely related to the temperature and granule size [20]. Therefore, it is necessary to investigate the impact of granule size on the partial nitrification performance. So far, the integrated relationship between the granule size, DO distribution, and partial nitrification performance has rarely been analyzed.
The aim of this study was to cultivate AGS for mainstream wastewater treatment under low temperature. The nutrient removal performance and sludge characteristics were investigated. Batch experiments were conducted to evaluate the substrate oxidization rate and nitrite accumulation rate (NAR) of mature AGS with different particle sizes. The DO distribution in AGS was further analyzed with microelectrode device. The results could provide important guidance for the rapid start-up of AGS reactors and the performance of high NAR in mainstream wastewater treatment.
2. Materials and Methods
2.1. Reactor Setup and Operation
As shown in Figure 1, the sequencing batch reactor (SBR) was used in the experiment. The reactor was of cylindrical structure, with an inner diameter of 8 cm, a height of 170 cm, an effective volume of 8 L, and a height diameter ratio of 21.2. The exchange ratio of the reactor was 50%. Aeration is carried out by the blast aeration pump, and the aeration rate was controlled to 2–3 L/min by the rotameter. In the aeration period, the DO concentration in the reactor reached 6 mg/L. The reactor temperature was controlled to 15 °C by water bath through the constant temperature cooling tank. The SBR operation procedures were: feeding (5 min), aeration (690 min), settling (adjusted as needed), and decant (10 min). The experiment was divided into two stages. In stage 1 (1–60 d), the aerobic granules were formed by reducing the settling time from 5 to 1 min. In stage 2 (61–100 d), the aerobic granular reactor achieved stable performance and the settling time was 1 min. The specific operating conditions are shown in Table 1.

Figure 1.
Schematic diagram of the AGS reactor: 1 Influent tank; 2 Influent pump; 3 AGS reactor; 4 Sampling port; 5 Drain valve; 6 Effluent; 7 PLC device; 8 Air pump; 9 Air flow meter; 10 pH/DO meter; 11 Temperature control tank.

Table 1.
Operational parameters of the AGS reactor.
2.2. Inoculated Sludge and Synthetic Wastewater
The inoculated sludge was the returned sludge (floc sludge) from the secondary sedimentation tank in Gaobeidian sewage treatment plant, Beijing, China. The initial mixed liquor suspended solids (MLSS) concentration in SBR was controlled at 4600 mg/L, and the sludge volume index (SVI30) of the inoculated sludge was 68 mL/g TSS. The reactor was fed with synthetic wastewater. The main components in the inlet water were sodium acetate and ammonium chloride. The chemical oxygen demand (COD) and NH4+-N concentrations were 300 and 60 mg/L, respectively. Other components were: CaCl2 40 mg/L, MgSO4·7H2O 20 mg/L, NaHCO3 720 mg/L, and 1 mL/L trace elements [1]. The components of trace elements were: FeCl3·6H2O 1500 mg/L, H3BO3 150 mg/L, CuSO4·5H2O 50 mg/L, Ki 150 mg/L, MnCl2·4H2O 110 mg/L, CoCl2·6H2O 150 mg/L, Na2MoO4·2H2O 60 mg/L, and ZnSO4·7H2O 120 mg/L.
2.3. Batch Experiment and Microelectrode Analysis
At the end of stage 2, mature aerobic granules were taken out from the reactor and screened to three categories: R1 (1.0–2.0 mm), R2 (2.0–3.0 mm), and R3 (larger than 3.0 mm). The batch experiment was carried out in the 500 mL serum bottle, and the mass transfer performance of the substrate was enhanced by magnetic stirring [21]. The synthetic wastewater used in the batch test was the same as the influent of the SBR reactor. The obtained granules of R1, R2, and R3 were added to three different serum bottles. The initial MLSS concentration was 4500 mg/L. The DO concentration was maintained at 5–6 mg/L and the temperature was controlled at 15 °C. Samples were taken at regular intervals to analyze COD and nitrogen concentrations.
The DO concentrations in R1, R2, and R3 granules were measured by microelectrodes. The microelectrode measurement device was the same as described by Meyer et al., (2003) [22] (Figure S1). The AGS were placed on the mesh in the flow tank. The synthetic wastewater used in the flow tank was the same as the influent of the SBR reactor. The DO concentration was controlled at 6–7 mg/Land the temperature was controlled at 15 °C.
2.4. Analytical Method
The NH4+-N, NO2−-N, NO3−-N, COD, and MLSS concentrations and SVI were determined with the standard methods [23]. The DO and temperature were measured by using the WTW 3420 device (Munich, Germany). SVI30 (mL/g TSS) was calculated after the activated sludge was settled for 30 min in a graduated cylinder. The total concentration of NH4+-N, NO2−-N, and NO3−-N concentrations was defined as the total nitrogen (TN) concentration. The DO concentration distribution in granules was measured by using commercial microsensors operated with a motorized micromanipulator (Unisense A.S., Aarhus, Denmark). The NAR was calculated by using the following equation:
2.5. Microbial Population Analysis
At the end of stage 2, the AGS were taken out from the reactor for microbial community analysis. High-throughput experiment was conducted by the Shanghai Shenggong Biological Engineering Co., Ltd. (Shanghai, China). The results of high-throughput sequencing were compared to the ribosomal database project (RDP) database and the taxonomic levels were assigned.
3. Results and Discussion
3.1. The AGS Reactor Performance and Sludge Characteristics
Figure 2 shows the nutrient removal performance of the AGS reactor. In stage 1 (1~60 d), the DO concentration in the reactor reached 6 mg/L, and the settling time was gradually reduced from 5 to 1 min. On the first day, the reactor had good ammonium removal performance. The effluent NH4+-N, NO2−-N, and NO3−-N concentrations were 0, 1.4, and 54.5 mg/L, respectively. However, from the second day to the 15th day, the effluent NH4+-N concentration gradually increased, indicating the decrease in NH4+-N removal performance. From the 16th day to the 30th day, theNH4+-N removal performance of the reactor was gradually recovered. On the 30th day, the effluent NH4+-N, NO2−-N, and NO3−-N concentrations were 2.6, 2.0, and 52.4 mg/L, respectively. From day 31 to day 60, the effluent NH4+-N concentration was lower than 3 mg/L. Meanwhile, the effluent NO3−-N concentration gradually decreased, while the effluent NO2−-N concentration gradually increased. On the 60th day, the effluent NH4+-N, NO2−-N, and NO3−-N concentrations were 1.3, 46.2, and 5.7 mg/L, respectively. In stage 2 (61–100 d), the DO concentration and settling time of the reactor was controlled at 6 mg/L and 1 min, respectively. The nutrient removal performance of the reactor remained stable. The average effluent NH4+-N, NO2−-N, and NO3−-N concentrations were 1.0, 47.2, and 5.1 mg/L, respectively. Meanwhile, the average NARof the effluent was 90.6%. Moreover, the average effluent TN concentration and TN removal efficiency were 52.4 mg/L and 15.0%, respectively. In the whole experiment, the reactor performed stable organic matter removal performance. The average effluent COD concentration and COD removal efficiency were 47.2 mg/L and 84.5%, respectively.

Figure 2.
Nutrient removal performance of the AGS reactor. (a) Nitrogen conversion and settling time, (b) TN removal performance, (c) COD removal performance.
Table 2 shows the changes in sludge characteristics in the reactor. From the first day to the 15th day, serious loss of sludge was observed due to the poor sedimentation performance of floc sludge. The MLSS concentration decreased from 4630to 1824 mg/L, and the SVI30 increased from 68 to 104 mL/g TSS. From the 16th day to the 60th day, the sludge concentration gradually increased and the sludge sedimentation performance was improved. On the 60th day, the MLSS concentration increased to 4356 mg/L, and the SVI30 decreased to 36 mL/g TSS. In stage 2 (61–100 d), the sludge concentration and SVI30 remained stable. On the 100th day, the sludge concentration and SVI30 were 4437 mg/L and 33 mL/g TSS, respectively. Figure 3 shows the morphology of AGS during the granular formation process. On the 30th, 60th, and 100th day, the average particle sizes of sludge reached 1.3, 3.2, and 3.5 mm, respectively.

Table 2.
Characteristics of granules during daily operation.
Figure 3.
Morphology of AGS during the granular formation process.
In low-strength wastewater treatment, previous studies showed that the low DO concentration in granules played an important role in the nitrite accumulation [17]. There are two main reasons for the low DO concentration in AGS. First, the DO concentration could be largely consumed by AOB and heterotrophic bacteria on the surface of granules [24,25]. In addition, the penetration depth of oxygen in granules was hindered due to the dense surface structure and large diffusion resistance of oxygen [16,26]. It has been proposed that the oxygen saturation constants of AOB and NOB were 0.2–0.4 mg/L and 1.2–1.5 mg/L, respectively [17,27]. As AOB had stronger oxygen affinity than NOB, the nitrite accumulation could occur at low DO concentration. In addition, the growth rate of AOB was accelerated at low DO concentration, which compensated for the decline in metabolic activity [28]. However, the growth rate and metabolic activity of NOB decreased significantly under low DO condition, favoring the accumulation of nitrite. In this study, the AOB activity would be greatly suppressed by low temperature. In order to improve the AOB activity, high DO concentration (6 mg/L) was maintained. In addition, the high air flow rate led to a higher water shear force, which was important to the fast cultivation of AGS. This was because the higher water shear force could stimulate the production of extracellular polymeric substances.
Under normal working conditions, the SVI value of activated sludge in wastewater treatment plant was between 70 and 100 mL/g TSS. The high SVI indicates poor sludge sedimentation, which will lead to sludge bulking. In this study, the SVI of mature AGS was much lower than the inoculated sludge. The start-up of the AGS reactor and sludge characteristics have been explored in early studies by using synthetic wastewater with sodium acetate and ammonia nitrogen. At room temperature, Corsino et al., (2016) have cultivated AGS in 120 days when the influent COD and NH4+-N concentrations were maintained at 900 and 90 mg/L, respectively [29]. By controlling the settling time at 5 min, the average particle size and SVI30 of the granules reached 1.3 mm and 30–40 mL/g TSS, respectively. Meanwhile, Deng et al., (2016) have developed the AGS reactor by gradually increasing the influent COD and NH4+-N concentrations [30]. The AGS was successfully cultivated in 30 days. Meanwhile, the particle size and SVI30 of the granules reached 0.8–1.1 mm and 30 mL/g TSS, respectively. As for low temperature, the proliferation of filamentous bacteria was observed in the AGS reactor [11]. By controlling the settling time to 5–3 min, the filamentous bacteria were successfully washed out. The particle size of the AGS increased to 4.5 mm after 60 days. Moreover, the AGS process was applied to treat industrial wastewater with high phenol and ammonium concentrations [31]. The influent phenol, NH4+-N, and SCN− concentrations were 400, 100, and 100 mg/L, respectively. After 35 days, the particle size and SVI30 of AGS reached 2938 μm and 35.25 mL/g TSS, respectively. As discussed above, the particle size and the sedimentation performance of AGS in this study were comparable to previous studies.
3.2. The Nutrient Removal Performance of Aerobic Granules
Figure 4 shows the nitrification performance of AGS with different particle sizes in batch experiments. The initial NH4+-N concentration was 60 mg/L. From 0 to 12 h, the NH4+-N concentration gradually decreased while the NO2−-N concentration gradually increased. After 12 h, the NH4+-N concentrations of R1, R2, and R3 reduced to 0, 15.1, and 28.0 mg/L, respectively. Meanwhile, the NO2−-N concentrations increased to 18.5, 24.8, and 18.6 mg/L, respectively. The NH4+-N removal efficiencies were 100.0%, 73.4%, and 52.7%, respectively. The NH4+-N removal rates were 0.85, 0.61, and 0.45 g N/(kg VSS·h), respectively. The results of batch experiment implied that the particle size had a significant impact on the ammonium oxidation rate. As the particle size increased, the NH4+-N removal performance of granular sludge gradually decreased. In addition, during the batch experiment, the NO3−-N concentrations of R1 and R2 began to increase rapidly after 2 and 6 h, respectively. However, the NO3−-N concentration of R3 was kept at a low concentration before the NH4+-N was entirely oxidized. At the end of the batch experiment, the NO3−-N concentrations of R1, R2, and R3 reached 32.7, 7.3, and 1.0 mg/L, respectively. Meanwhile, the NARs were 36.2%, 77.2%, and 94.9%, respectively. The larger granules performed higher nitritation performance than the smaller granules.

Figure 4.
Performance of R1 (1.0–2.0 mm), R2 (2.0–3.0 mm), and R3 (larger than 3.0 mm) granules in batch test.
3.3. DO Distribution in AGS
Figure 5 shows the DO distribution in AGS with different particle sizes. The DO concentration in the water phase was 6.6 mg/L. From the surface of the AGS to the inner part of the AGS, the DO concentration gradually decreased. The particle size of R1 granule was 1066 μm, and the lowest DO concentration was 1.32 mg/L. The particle size of R2 granule was 2292 μm. The DO concentrations reduced to 0.5and 0 mg/L at the distances of 582 and 700 μm from the surface of the granules, respectively. The particle size of R3 granule was 3048 μm. The DO concentrations reduced to 0.5 and 0 mg/L at the distances of 606 and 700 μm from the surface of the granules, respectively. In R1, R2, and R3 granules, the low DO concentration area (DO < 0.5 mg/L) accounted for 0%, 11.9%, and 21.8% of the total volume of granular sludge, respectively. Kishida et al., (2006) found that the oxygen penetration depth in granules was 100 μm when the temperature and DO concentration in the bulk liquid were 20 °C and 5.5 mg/L, respectively [32]. Meanwhile, Rathnayake et al., (2013) reported that the oxygen penetration depth in granules was 300 μm when the temperature and DO concentration in the bulk liquid were 30 °C and 2 mg/L, respectively [16]. Morales et al., (2015) proposed that the DO concentration in the bulk liquid had a significant impact on the DO concentration distribution in granules [19]. In their study, the SNAD granular sludge reactor operated at 25 °C. The microelectrode analysis results showed that the oxygen penetration depths in granules were 150 and 250 μm when the DO concentrations in the bulk liquid were controlled at 4 and 8 mg/L, respectively. In this study, the AGS reactor was operated at 15 °C, and the oxygen penetration depth in granules was much larger than previous studies. De kreuk et al., (2005) also proposed that the low temperature led to a larger oxygen penetration depth [20]. As the low DO concentration area (DO < 0.5 mg/L) in R3 granules wan only 21.8%, the low DO concentration might not be the main factor for the NOB activity inhibition.

Figure 5.
DO distribution in R1 (1.0–2.0 mm), R2 (2.0–3.0 mm), and R3 (larger than 3.0 mm) granules.
Apart from the low DO condition, some studies have shown that the NOB activity could be seriously inhibited by NO [33,34]. Starkenburg et al., (2008) reported that the Nitrobacter activity could be inhibited when the NO concentration was maintained at 7–448 μg N/L [33]. It was found that the nitrite affinity of NOB was closely related to the inhibitory effect of NO [34]. By maintaining the NO concentration at 2 μg N/L, the NOB activity was inhibited by 30–50% and 60–80% when the nitrite saturation constants of NOB were 0.36 and 0.06 mg/L, respectively. In sewage treatment, there are three main ways to produce NO: (1) the hydroxylamine pathway; (2) the nitrifier denitrification; and (3) the heterotrophic denitrification. In the nitrification process, ammonium was first oxidized to hydroxylamine, and the hydroxylamine was further oxidized to NO [35]. According to previous studies, the copper-containing nitrite reductase (NirK) found in AOB was important in converting NO2−-N to NO, and the NirK gene was actively expressed under low DO and high nitrite concentrations [36,37]. During the denitrification process, the NO2−-N was reduced to NO by NirK, and the NO was further reduced to N2O by the NO reductase (NOR). The NirK gene of denitrifiers was over expressed under high nitrite concentrations and the NOR could be severely inhibited by oxygen, which might lead to NO accumulation [35]. Based on the discussion above, the low DO and high nitrite concentrations were favorable for NO accumulation. In this study, the low DO concentration area (DO < 0.5 mg/L) in R3 granules was much larger than the R1 granules. The NOB activity in larger granules might be inhibited by the production of high NO concentration. Therefore, it is necessary to further investigate the NO distribution in granular sludge.
3.4. Microbial Community Analysis in Aerobic Granular Sludge
Figure 6 shows the microbial community analysis results of aerobic granular sludge. The dominant phyla in granular sludge were Proteobacteria (54.61%), Bacteroidetes (17.43%), Saccharibacteria (5.28%), Planctomycetes (2.87%), Verrucomicrobia (2.36%), Chloraflexi (1.04%), Firmicutes (0.53%), and Acidobacteria (0.26%). The most abundant phyla were Proteobacteria and Bacteroidetes, which was similar to previous study [1]. The dominant genera were Paracoccus (8.51%), Bacillus (6.11%), Solibacillus (5.98%), Thaurea (3.66%), Azoarcus (2.83%), Gemmobacter (1.57%), Acinetobactor (1.22%), Pesudoxanthomonas (1.01%), Pesudomonas (0.79%), Meganema (0.76%), and Nitrosomonas (0.57%). Table 3 shows the abundance of AOB and NOB in granular sludge. The abundance of AOB in granular sludge was much higher than that of NOB. The AOB genera were Nitrosomonas (0.57%) and Nitrosospira (0.24%), while the NOB genera were Nitrobacter (0.07%) and Nitrospira (0.04%), respectively.

Figure 6.
Microbial species at phylum and genus levels.

Table 3.
Nitrogen removal bacteria communities at the genus level.
4. Conclusions
The AGS reactor was developed under low temperature in the SBR. The SVI30 and particle size of granular sludge reached 33 mL/g TSS and 3.5 mm, respectively. The particle size of AGS had a significant impact on the NH4+-N removal rate and nitritation performance. When the DO concentration in the bulk liquid was 6–7 mg/L, the microelectrode analysis results showed that the penetration depth of oxygen was 700 μm. The larger granules performed higher NAR than the smaller granules. The low DO concentration in larger AGS might not be the direct reason for NOB inhibition. The low DO concentration area in larger AGS and high nitrite concentration in bulk liquid were favorable for NO accumulation, which might play an important role in inhibiting NOB activity. The abundance of AOB and NOB in mature AGS were 0.81% and 0.11%, respectively.
Supplementary Materials
The following are available online at https://www.mdpi.com/article/10.3390/w13243590/s1, Figure S1: Configuration of the microsensor device.
Author Contributions
Project Administration, J.L.; funding acquisition, J.L.; conceptualization, Z.Z. and D.L. (Dongbo Liang); methodology, Z.Z.; investigation, D.L. (Dongbo Liang) and D.L. (Dongyue Li); writing—original draft preparation, Z.Z. and J.Z.; data curation, D.L. (Dongbo Liang); review and editing, K.Z., Y.W. and P.L. All authors have read and agreed to the published version of the manuscript.
Funding
This research was funded by the Beijing Chaoyang District Postdoctoral Research Foundation (No. 2020-ZZ-11), and the Beijing Postdoctoral Research Foundation (No. 2020-ZZ-112).
Institutional Review Board Statement
Not applicable.
Informed Consent Statement
Not applicable.
Data Availability Statement
The data presented in this study are available on request from the corresponding author. The data are not publicly available due to privacy.
Acknowledgments
We thank the reviewers for their useful comments and suggestions.
Conflicts of Interest
The authors declare no conflict of interest.
References
- Xu, J.; Pang, H.L.; He, J.G.; Nan, J.; Wang, M.F.; Li, L. Start-up of aerobic granular biofilm at low temperature: Performance and microbial community dynamics. Sci. Total Environ. 2020, 698, 134311. [Google Scholar] [CrossRef] [PubMed]
- Maktabifard, M.; Zaborowska, E.; Makinia, J. Energy neutrality versus carbon footprint minimization in municipal wastewater treatment plants. Bioresour. Technol. 2020, 300, 122647. [Google Scholar] [CrossRef] [PubMed]
- Wang, Z.Y.; Zheng, M.; Hu, Z.T.; Duan, H.R.; De Clippeleir, H.; Al-Omari, A.; Hu, S.H.; Yuan, Z.G. Unravelling adaptation of nitrite-oxidizing bacteria in mainstream PN/A process: Mechanisms and counter-strategies. Water Res. 2021, 200, 117239. [Google Scholar] [CrossRef] [PubMed]
- Tomar, S.K.; Chakraborty, S. Comparison of rapid granulation developed from the same industrial sludge with two different substrates. Int. Biodeter. Biodegr. 2019, 142, 218–226. [Google Scholar] [CrossRef]
- Wei, D.; Ngo, H.H.; Guo, W.S.; Xu, W.Y.; Du, B.; Wei, Q. Partial nitrification granular sludge reactor as a pretreatment for anaerobic ammonium oxidation (Anammox): Achievement, performance and microbial community. Bioresour. Technol. 2018, 269, 25–31. [Google Scholar] [CrossRef]
- Mulder, J.W.; van Loosdrecht, M.; Hellinga, C.; van Kempen, R. Full-scale application of the SHARON process for treatment of rejection water of digested sludge dewatering. Water Sci. Technol. 2001, 43, 127–134. [Google Scholar] [CrossRef]
- Laureni, M.; Weissbrodt, D.G.; Villez, K.; Robin, O.; de Jonge, N.; Rosenthal, A.; Wells, G.; Nielsen, J.L.; Morgenroth, E.; Joss, A. Biomass segregation between biofilm and flocs improves the control of nitrite-oxidizing bacteria in mainstream partial nitritation and anammox processes. Water Res. 2019, 154, 104–116. [Google Scholar] [CrossRef]
- Jiang, H.; Yang, P.; Wang, Z.; Ren, S.; Qiu, J.G.; Liang, H.R.; Peng, Y.Z.; Li, X.Y.; Zhang, Q. Novel insights into overcoming nitrite oxidation bacteria acclimatization problem in treatment of high-ammonia wastewater through partial nitrification. Bioresour. Technol. 2021, 336, 125254. [Google Scholar] [CrossRef]
- Muñoz-Palazon, B.; Rodriguez-Sanchez, A.; Hurtado-Martinez, M.; Gonzalez-Lopez, J.; Pfetzing, P.; Gonzalez-Martinez, A. Performance and microbial community structure of aerobic granular bioreactors at different operational temperature. J. Water Process Eng. 2020, 33, 101110. [Google Scholar] [CrossRef]
- Xu, J.; He, J.G.; Wang, M.F.; Li, L. Cultivation and stable operation of aerobic granular sludge at low temperature by sieving out the batt-like sludge. Chemosphere 2018, 211, 1219–1227. [Google Scholar] [CrossRef]
- Gonzalez-Martinez, A.; Muñoz-Palazon, B.; Rodriguez-Sanchez, A.; Maza-Márquez, P.; Mikola, A.; Gonzalez-Lopez, J.; Vahala, R. Start-up and operation of an aerobic granular sludge system under low working temperature inoculated with cold-adapted activated sludge from Finland. Bioresour. Technol. 2017, 239, 180–189. [Google Scholar] [CrossRef]
- Gong, Q.T.; Wang, B.; Gong, X.F.; Liu, X.F.; Peng, Y.Z. Anammox bacteria enrich naturally in suspended sludge system during partial nitrification of domestic sewage and contribute to nitrogen removal. Sci. Total Environ. 2021, 787, 147658. [Google Scholar] [CrossRef]
- Wang, F.; Xu, S.H.; Liu, L.J.; Wang, S.Y.; Ji, M. One-stage partial nitrification and anammox process in a sequencing batch biofilm reactor: Start-up, nitrogen removal performance and bacterial community dynamics in response to temperature. Sci. Total Environ. 2021, 772, 145529. [Google Scholar] [CrossRef]
- Vazquez-Padin, J.R.; Figueroa, M.; Campos, J.L.; Mosquera-Corral, A.; Mendez, R. Nitrifying granular systems: A suitable technology to obtain stable partial nitrification at room temperature. Sep. Purif. Technol. 2010, 74, 178–186. [Google Scholar] [CrossRef]
- Zhang, J.H.; Zhang, Q.; Miao, Y.Y.; Sun, Y.W.; Chen, J.F.; Peng, Y.Z. Stable and efficient partial nitritation granular sludge reactor treating domestic sewage at low temperature. Bioresour. Technol. 2018, 270, 746–750. [Google Scholar] [CrossRef]
- Rathnayake, R.M.L.D.; Song, Y.; Tumendelger, A.; Oshiki, M.; Ishii, S.; Satoh, H.; Toyoda, S.; Yoshida, N.; Okabe, S. Source identification of nitrous oxide on autotrophic partial nitrification in a granular sludge reactor. Water Res. 2013, 47, 7078–7086. [Google Scholar] [CrossRef] [Green Version]
- Blackburne, R.; Yuan, Z.G.; Keller, J. Partial nitrification to nitrite using low dissolved oxygen concentration as the main selection factor. Biodegradation 2008, 19, 303–312. [Google Scholar] [CrossRef]
- Layer, M.; Villodres, M.G.; Hernandez, A.; Reynaert, E.; Morgenroth, E.; Derlon, N. Limited simultaneous nitrification-denitrification (SND) in aerobic granular sludge systems treating municipal wastewater: Mechanisms and practical implications. Water Res. X 2020, 7, 100048. [Google Scholar] [CrossRef]
- Morales, N.; Del Rio, A.V.; Vazquez-Padin, J.R.; Gutierrez, R.; Fernandez-Gonzalez, R.; Icaram, P.; Rogalla, F.; Campos, J.L.; Mendez, R.; Mosquera-Corral, A. Influence of dissolved oxygen concentration on the start-up of the anammox-based process: ELAN (R). Water Sci. Technol. 2015, 72, 520–527. [Google Scholar] [CrossRef]
- de Kreuk, M.K.; Pronk, M.; van Loosdrecht, M. Formation of aerobic granules and conversion processes in an aerobic granular sludge reactor at moderate and low temperatures. Water Res. 2005, 39, 4476–4484. [Google Scholar] [CrossRef]
- Zheng, Z.M.; Li, J.; Chen, G.H.; Peng, Y.Z. Exploring the optimized strategy in the nitritation-anammox biofilm process for treating low ammonium wastewater. Bioresour. Technol. 2021, 319, 124113. [Google Scholar] [CrossRef]
- Meyer, R.L.; Saunders, A.M.; Zeng, R.J.; Keller, J.; Blackall, L.L. Microscale structure and function of anaerobic—Aerobic granules containing glycogen accumulating organisms. FEMS Microbiol. Ecol. 2003, 45, 253–261. [Google Scholar] [CrossRef]
- APHA. Standard Methods for the Examination of Water and Wastewater, 21st ed.; American Public Health Association: Washington, DC, USA, 2005. [Google Scholar]
- Dapena-Mora, A.; Fernandez, I.; Campos, J.L.; Mosquera-Corral, A.; Mendez, R.; Jetten, M. Evaluation of activity and inhibition effects on Anammox process by batch tests based on the nitrogen gas production. Enzym. Microb. Tech. 2007, 40, 859–865. [Google Scholar] [CrossRef]
- Li, J.; Guo, J.S.; Fang, F.; Chen, Y.P.; Zhang, Q. Effect of organic carbon on nitrogen conversion and microbial communities in the completely autotrophic nitrogen removal process. Environ. Technol. 2012, 33, 1141–1149. [Google Scholar]
- Vazquez-Padin, J.R.; Fernandez, I.; Morales, N.; Campos, J.L.; Mosquera-Corral, A.; Mendez, R. Autotrophic nitrogen removal at low temperature. Water Sci. Technol. 2011, 63, 1282–1288. [Google Scholar] [CrossRef]
- Guisasola, A.; Jubany, I.; Baeza, J.A.; Carrera, J.; Lafuente, J. Respirometric estimation of the oxygen affinity constants for biological ammonium and nitrite oxidation. J. Chem. Technol. Biot. 2005, 80, 388–396. [Google Scholar] [CrossRef]
- Kornaros, M.; Dokianakis, S.N.; Lyberatos, G. Partial Nitrification/Denitrification Can Be Attributed to the Slow Response of Nitrite Oxidizing Bacteria to Periodic Anoxic Disturbances. Environ. Sci. Technol. 2010, 44, 7245–7253. [Google Scholar] [CrossRef]
- Corsino, S.F.; Capodici, M.; Torregrossa, M.; Viviani, G. Fate of aerobic granular sludge in the long-term: The role of EPSs on the clogging of granular sludge porosity. J. Environ. Manag. 2016, 183, 541–550. [Google Scholar] [CrossRef] [PubMed] [Green Version]
- Deng, S.; Wang, L.X.; Su, H.J. Role and influence of extracellular polymeric substances on the preparation of aerobic granular sludge. J. Environ. Manag. 2016, 173, 49–54. [Google Scholar] [CrossRef] [PubMed]
- Tomar, S.K.; Chakraborty, S. Effect of air flow rate on development of aerobic granules, biomass activity and nitrification efficiency for treating phenol, thiocyanate and ammonium. J. Environ. Manag. 2018, 219, 178–188. [Google Scholar] [CrossRef]
- Kishida, N.; Kim, J.; Tsuneda, S.; Sudo, R. Anaerobic/oxic/anoxic granular sludge process as an effective nutrient removal process utilizing denitrifying polyphosphate-accumulating organisms. Water Res. 2006, 40, 2303–2310. [Google Scholar] [CrossRef] [PubMed]
- Starkenburg, S.R.; Arp, D.J.; Bottomley, P.J. Expression of a putative nitrite reductase and the reversible inhibition of nitrite-dependent respiration by nitric oxide in Nitrobacter winogradskyi Nb-255. Environ. Microbiol. 2008, 10, 3036–3042. [Google Scholar] [CrossRef]
- Emilie, N.P.C.; Haydée, D.C.; Siegfried, E.V.; Robin, J.; Hongkeun, P.; Kartik, C.; Nico, B. Nitric oxide preferentially inhibits nitrite oxidizing communities with high affinity for nitrite. J. Biotechnol. 2015, 193, 120–122. [Google Scholar]
- Castro-Barros, C.M.; Rodriguez-Caballero, A.; Volcke, E.I.P.; Pijuan, M. Effect of nitrite on the N2O and NO production on the nitrification of low-strength ammonium wastewater. Chem. Eng. J. 2016, 287, 269–276. [Google Scholar] [CrossRef]
- Anna, R.; Maite, P. Distinctive NO and N2O emission patterns in ammonia oxidizing bacteria: Effect of ammonia oxidation rate, DO and pH. Chem. Eng. J. 2017, 321, 358–365. [Google Scholar]
- Yu, R.; Kampschreur, M.J.; van Loosdrecht, M.C.M.; Chandran, K. Mechanisms and Specific Directionality of Autotrophic Nitrous Oxide and Nitric Oxide Generation during Transient Anoxia. Environ. Sci. Technol. 2010, 44, 1313–1319. [Google Scholar] [CrossRef]
Publisher’s Note: MDPI stays neutral with regard to jurisdictional claims in published maps and institutional affiliations. |
© 2021 by the authors. Licensee MDPI, Basel, Switzerland. This article is an open access article distributed under the terms and conditions of the Creative Commons Attribution (CC BY) license (https://creativecommons.org/licenses/by/4.0/).